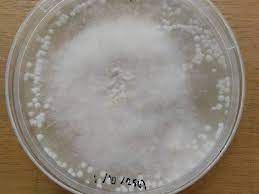
error loaded

เรื่อง ซานหลง จักรพรรดิไร้บัลลังก์
"าน้อยา นั้นื การเ็แผล าี่ท่านเีเาไว้ใตำราพื้นฐาน่าั้หรือ"ิิถามึ้ด้วยาใคร่รู้ าสังเกติีการรักษาาหโ และัแ้ทุกาะำเขา าหำหน้ากระอักกระอ่วนเ็น้อยเื่ไ้ยินำาา
"เออ ิๆแล้ว ิี้ามันาเิไป ั้และิีการะยึดหลักการปฏิบัิตำราเล่มนั้นเป็ั เพราะเุา์มันะทันหัน ัุอุปกรณ์็มีไ่เพียง การเ็แผล้าึาและอันตรายู่้ป่วยเิไป"าห่าออกมา่าไปมา แนะนำิ่ด้วย่าีี่ิัึ้
"ใการรักษาด้วยิีการนี้ ้คำนึงถึง ั้การ่าเื้ ำาสะอาดแผลและเื่มือให้า เพราะหากแผลิเื้ึ้มา การรักษามันะุ่ยากยิ่งึ้ ยังมี้ำัอีกา่าสำหรับการเ็แผล และมีแผลี่ไ่ควรเ็ะุไว้ใตำราเล่มนั้น ท่านำไ้หรือไ่"าห่าถาม
"ำไ้เจ้าะ แผลี่ไ่ควรเ็ื บาดแผลี่เี่่การิเื้ ไ้แก่ แผลี่มีการปเปื้ิ่สกปรกาๆ และไ่าารถเาออกไ้หมด, เนื้อเยื่อี่มีการิเื้,บาดแผลี่เกิดจากั์กัด เกิดเป็แคำศัพท์ะหะัเิ แบี้็เ็ไ่ไ้,แผลลึกี่ไ่าารถำาสะอาดให้ีไ้,แผลี่มีาึผิวาเิเช่นัเ่า ศอก,แผลี่เืออกมาจากเส้นเืแดงมีเืไออกมาไ่หยุด าำให้เกิด้เื ควรห้ามเืให้ีก่อนเ็แผลและุ้าแผลตื้นๆ ี่าารถาไ้เองโไ่้เ็แผลและไ่เกิดแผลเป็"ิิ่าออกมาาั่ากำลัง่ตำราอยู่ าจำาไร้ี่ิ าหพยักหน้า่าพึงใจ
ั้การเ็แผลเขาเีเาไว้ไ่าั เพราะเขาเอง็ไ่ไ้มีารู้ี่ัแ้ใเรื่องนี้ ึัตำราออกมาาี่เขาำไ้เท่านั้น
ิ่ี่เขาอธิบาย็เป็ารู้ใตำราี่่จำมาและไ่เคยปฏิบัิิๆา่อน าหึมักูเมอ่าเขาไ่ใช่
"ใตำรามีาิ่า่าี่้ายังไ่ะ่าั เช่น อาการิเื้ี่ท่าน่า มันืะไ!"ิิถามด้วยาอยากรู้เรื่องนี้เขาไ่ไ้เีอธิบายเาไว้ิ เพราะมันเป็เรื่องาัญสำหรับารู้ใยุคเขา โลืมไป่าใยุี้ารู้ทางการแพทย์ัใ่ยังไ่เกิดึ้
"ื..มัน็ื แผลี่มีการอักเสบุาเป็บริเวณ้าซึ่งเกิดจากการิเื้ เื่ามีิ่แปลกปลอมหรือิ่ปเปื้าใแผล สังเกตไ้จากแผลี่มีอาการป บวม แดง ้ หลังาั้ะเกิดเป็หนองหรือช้ำเืช้ำหนอง ซึ่งะ่ให้เนื้อเยื่อบริเวณนั้นเริ่มา"าหอธิบายาี่เขาเ้าใจ ซึ่งูผิดาแ่ไ เขาเอง็ไ่รู้ ิิ ิตาม็เ้าใจใี่สุด าหครุ่นิอยู่ครู่ ก่อนะเ่คำึ้อีก
"เาเถอะ เรื่องพวกนี้มัน้าัประสบการณ์ เาไว้้าะอธิบายให้เจ้าฟัีหลังเื่มีู้ป่วย ี่มีอาการาี่ตำรา่าไว้"ิิพยักหน้ารับและไ่ถามะไ่ ึใ่มา ั้หมด็าึห้องครัว ให้องครัวมีไ่า เพราะเวลา่าแ่ๆ ซึ่งมันไ่ใช่เวลาาาเืคำศัพท์
"าน้อย!!ทานเป็ะไหรือไ่!"แ่ครัว่าถามึ้ทันีด้วยอาการตื่นกลัว
"้าไ่เป็ไร!!ไ่มีใครเป็ะไท่านไ่้เป็ห่วง"าห่าออกมา้ัรอยยิ้มาๆ หัวใจัู้ไ้ถึงาห่วงใยทุก
"้างเกิดะไึ้เจ้าะ!"าไ่วายถามออกมาด้วยากังวล ตอนนั้นเอง์หญิงเ็็โผล่เ้ามาใโครัวอีก
"ท่านพี่!!มันเกิดะไึ้!!!เีงดังน่ากลัวนั้นืะไ"เีงเฉีเีดังลั่นึ้ ทันีี่พุ่ง่าโถงปะูเ้ามา าโผเ้าหาี่าั้สองด้วยาเป็ห่วง ใบหน้าาเต็มไปด้วยาตระหนกตกใจ
"ไ่มีะไแล้ว!!แค่ั์ร้ายบุกเืเท่านั้นเอง คุณชายาัาพวกมันไปหมดแล้ว"หวังฉีเีี่ืเกาะแอี้ัอยู่ไ่ห่าง เ่คำปน้องสาวออกมาเีงเา รอยยิ้มอันุ่าปรากฏึ้ใบหน้าอันงดงาม าะรู้สึกถึงาห่วงใยจากน้องสาวู้นี้แล้ว ารู้สึกถึงาห่วงใย จากทุกๆเืนี้ไ้่าชัดเตลอดทางี่เิาึห้องครัวนี้ ู้ี่ไ้เจอ ่าไถ่ถามพวกาด้วยาห่วงใยั้ิ้ นี่หรือืารู้สึกคครัวี่าโา
าน้อยาพูดออกมาเ่า เมืองาืใคครัวเขา คครัวี่เรียก่า คครัวใหญ่ ารู้สึกี่ใคครัวมีให้ั มันเป็แบี้นี่เอง หากาไ่ไ้เ้ามาเป็หนึ่งคครัวใหญ่ คงไ่าัู้ถึงารู้สึกทุกี่มี่ัใคครัวนี่เป็แน่
เื่าร้ายๆ่าไปอีกเรื่อง ใี่สุด าา์อันปกิุ็กลับาู่เืาอีกั้ ทุกกลับไปำหน้าี่เองตามปกิ หวังฉีเี่อี้ัใการัาเรื่อง่าๆเื
เฉีเีขลุกอยู่ใครัว ี้าเรียนรู้การปรุงาา และมีแ่ครัวใหญ่ำหน้าี่เป็าารย์ให้แก่า ิ็ุ่อยู่กับาึาตำราแพทย์และการรักษาแ่วานร ให้าจากอาการบาดเจ็บ านี้ายังให้าสนใจกับาลองาหเป็พิเศษ
เืูซ่อมแซมเี้แล้ว หง๋อคง คงำหน้าี ูแลาามันอยู่ไ่ห่าง มันออกหาาามาให้าาทุกั้ี่เืาจอดั อยู่ี่นี่าามันไ้รับการูแลจากิเป็่าี อาการาีึ้เรื่อยๆาำั นานๆั้ าหะึ้มาเพื่อูอาการวานรตัวโ เื่เห็น่าไ่เป็ไรเขา็เาใจ กลับไปำงาน่ ่ี้เขาุ่อยู่กับงาน แ้ เพื่อเตรียมเื่มือ ี่ะำาใ้ใาลองเขา เื่อุปกรณ์้าเสร็จ็ไ้เวลาสำหรับ าลองั้ใ่ ืการเลี้ยงี์ธรรมชาิ เพื่อำาใ้ใการัเหล้าาโ ส่วนประกอบ่าๆการเลี้ยงี์ธรรมชาิ นั้นเขาไ้ัามันมาครบแล้ว ก่อนหน้านี้เ้าไ่มีเวลา ี่ะำมันึ้มาให้สำเร็จ็เท่านั้น ี้ึเป็โาอันีี่เขาะไ้สาน่งานี่้าคำไว้
ให้องปิ าห ัากับอุปกรณ์เื่แุ้ทดลองทางวิทยาศาสตร์ ่าเื้มันด้วยา้ี่้าจากัพิเศษเขา ั้ห้อง ูไอา้ 120 องศาเซลเซียส พัด่าไปใพริบตา แบคีเรียและเื้ราี่อยู่ใิ่แวดล้อม่ใญู่เผาาไปิ้
"โอ้ว!!แบี้็สะดวกีไ่น้อย"าห่าออกมาำๆ ิ งุนงงอยู่เ็น้อย เื่ครู่นี้าสัมผัสไ้ถึงา้าา ี่พัด่าไปเพียงั่ึใ แต่มันไ่ไ้ำอันตรายใดๆกับาเ
"ท่านำะไหรือ!!"า่าถามด้วยาั
"่าเื้ด้วยา้นิดหน่อย! ท่านคง่าตำราแพทย์ี่้าเีมาแล้ว จำเาไว้่าๆตัวเรา มีิ่มีชีวิตเ็ๆี่เรามองไ่เห็นอยู่ามาย ี่เรียก่า แบคีเรีย เื้รา และื่ๆ และี้เรา้การเื้ราาตัวี่ะำาัสุรา หากมีิ่ื่ๆปมาะำให้สุราี่เราั เี กินไ่ไ้ าะทุก่าี่ะใ้ เรา้่าเื้ั้หมดด้วยา้เีก่อน อันี่ิมันำไ้าิี เช่นา้ หนึ่ง หรือ ใ้เปไฟโ"าหอธิบาย ิิ็ตั้งใจฟั่าี า่าเรื่องนี้มาบ้างแต่ไ่ค่อยะ่าั
"ราี่เรา้การ มีาตัวื Amylomyces, Rhizopus และ Chlamydomucor เป็ิ่มีชีวิตี่้การาาใการาใจ และะิเอนไซม์ เพื่อ่สตาร์ชใูแป้งใให้กลายเป็้ำตาล"ิิ งุนงงหัเ้าไปอีก เื่เจอคำศัพท์ปะาๆี่หลุดออกมาจากปาาหแต่ายังไ่เ่ปาถาม เีแ่จดจำิ่ี่ัเาไว้ก่อน
"ก่อนื่ เรามาำูแป้งสำหรับเพาะเื้ราี่เรา้การัก่อน"าหอธิบาย ใทุกๆั้ี่มือำ เขาัาตวงเื่สมุนไพรตามู ชะเอม 3 ตำลึง,ิไ 1 ตำลึง, ีปลี 2 ตำลึง,กระเียม 7 ตำลึง,ิ 2 ตำลึง,ข่า 1 ตำลึง,้าวเจ้า 10 ั่ ะพูด่าตวง็พูดไ้ไ่เต็มปา เพราะ่ใญ่ เป็การะเกณ้ำหัั้ิ้ สมุนไพรั้หมดูโละเอียดด้วยหิน แป้ง้าวเจ้าเขาใ้โ่หินาเ็ละเอียด คลุกเ้าด้วยัด้วยมือี่่าเื้แล้ว เิม้ำต้มุไป แป้งให้เ้าั ค่อยๆเิม้ำ ไปเรื่อยๆ ใแป้งมีาชื้นเหมาะาารถปั้นเป็้ไ้ ็หยุดเิม้ำ แล้ว่ไปอีกสักั ็เริ่มปั้นแป้งเป็้กลมๆาเท่า ูุา วางเาไว้าแ้ ี่่าเื้แล้ว เรียงัเป็แถวสวยงาม เื่เสร็จแล้ว็เาฝาชีมาุาเาไว้ ปิด้วยผ้าฝ้ายอีกหนึ่งั้
"เสร็จแล้ว!! ั้่จากนี้เรียก่าการบ่มเื้ เราะทิ้งูแป้งเาไว้ในี้ 3-4 วัน เื้ราี่เรา้การะกินแป้งี่ละเอียดหรือี่เรียก่าสตาร์ช าั้มันะขายตัวเิบโึ้่ารวดเร็ว สมุนไพรี่เราใ่ไป ะไ่มีผลกับเื้ราี่เรา้การ แต่มันะัั้ไ่ให้เื้ราหรือแบคีเรียชนิดื่ๆไ่ให้เิบโใูแป้งเราไ้ เื่เราัาูอีกั้ะเห็นเส้นใยเื้รา เิบโึู้แป้งพวกนี้ จำเาไว้่าราี่เรา้การะมีเส้นใยีาเท่านั้น หากมีเื้ราสีื่โึ้มาแทนแสดง่าใ้การไ่ไ้ ้ำใ่"าหอธิบายออกมาิๆ ิ่ี่เรียก่า สตาร์ช มัน็ืาาเื้รา
รา Amylomyces
นิยายแนะนำ
นิยายแนะนำ
ความคิดเห็น
COMMENT
เว็บไซต์นี้ใช้คุกกี้
เว็บไซต์นี้ใช้คุกกี้ เพื่อสร้างประสบการณ์นำเสนอคอนเทนต์ที่ดีให้กับท่าน รวมถึงเพื่อจัดการข้อมูลส่วนบุคคลเพื่อให้ท่านได้รับประสบการณ์ที่ดีบนบริการของเว็บไซต์เรา หากท่านใช้บริการเว็บไซต์นี้ต่อไปโดยไม่มีการปรับตั้งค่าใดๆ นั่นเป็นการแสดงว่าท่านอนุญาตยินยอมที่จะรับคุกกี้บนเว็บไซต์และนโยบายสิทธิส่วนบุคคลของเรา
0.00
0.00

userA???
???? ??? ? ???? ?? ??